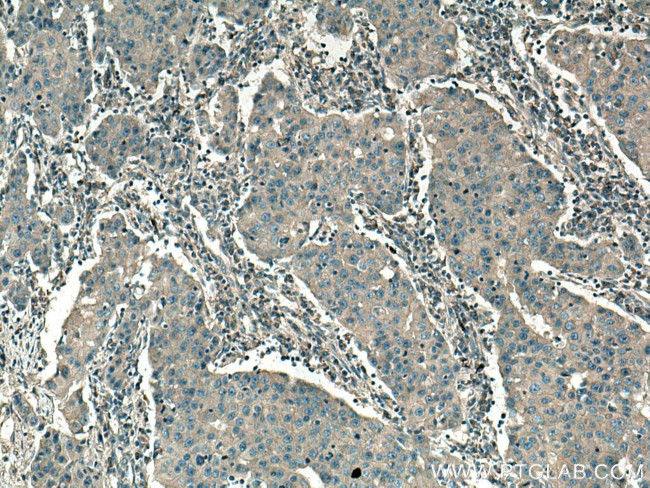
SAP 97 Antibody in Immunohistochemistry (Paraffin) (IHC (P))

Search
Proteintech
SAP 97 Polyclonal Antibody
{{$productOrderCtrl.translations['antibody.pdp.commerceCard.promotion.promotions']}}
{{$productOrderCtrl.translations['antibody.pdp.commerceCard.promotion.viewpromo']}}
{{$productOrderCtrl.translations['antibody.pdp.commerceCard.promotion.promocode']}}: {{promo.promoCode}} {{promo.promoTitle}} {{promo.promoDescription}}. {{$productOrderCtrl.translations['antibody.pdp.commerceCard.promotion.learnmore']}}
产品信息
29292-1-AP150UL
种属反应
宿主/亚型
分类
类型
偶联物
形式
浓度
规格
纯化类型
保存液
内含物
保存条件
运输条件
靶标信息
This gene encodes a multi-domain scaffolding protein that is required for normal development. This protein may have a role in septate junction formation, signal transduction, cell proliferation, synaptogenesis and lymphocyte activation. Several alternatively spliced transcript variants encoding different isoforms have been described for this gene, but the full-length nature of some of the variants is not known.
仅用于科研。不用于诊断过程。未经明确授权不得转售。
篇参考文献 (0)
生物信息学
蛋白别名: discs large homolog 1, scribble cell polarity complex component; Disks large homolog 1; dJ1061C18.1.1; DKFZp761P0818; DKFZp781B0426; hDlg; presynaptic protein SAP97; SAP-97; Synapse-associated protein 97; unnamed protein product
基因别名: DLG1; DLGH1; hdlg; SAP-97; SAP97
UniProt ID: (Human) Q12959
Entrez Gene ID: (Human) 1739